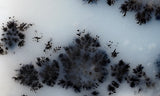
Mexican Dendritic Opal Slab 28

Mexican Dendritic Opal Slab 28
Dendritic opal, from Mexico, is a unique form of common that displays distinctive dendritic patterns imbedded in semi-transparent or milky white opal matrix. The dendrites are fern-like inclusions of iron, manganese, or other metallic oxides that create bold patterns within the gem.
Dendritic opal was used by ancient civilizations for tools, jewelry, and other items. Today it’s still popular and is among the most sought-after forms of natural gemstones because they are so incredibly beautiful and unique.
Origin: Mexico
Dimensions: 2" x 1.75" and approximately 6.5 mm thick. Weight = 21 grams.
Shown wet. Not polished. Known flaws are shown as white lines in the final picture frame.
We Also Recommend